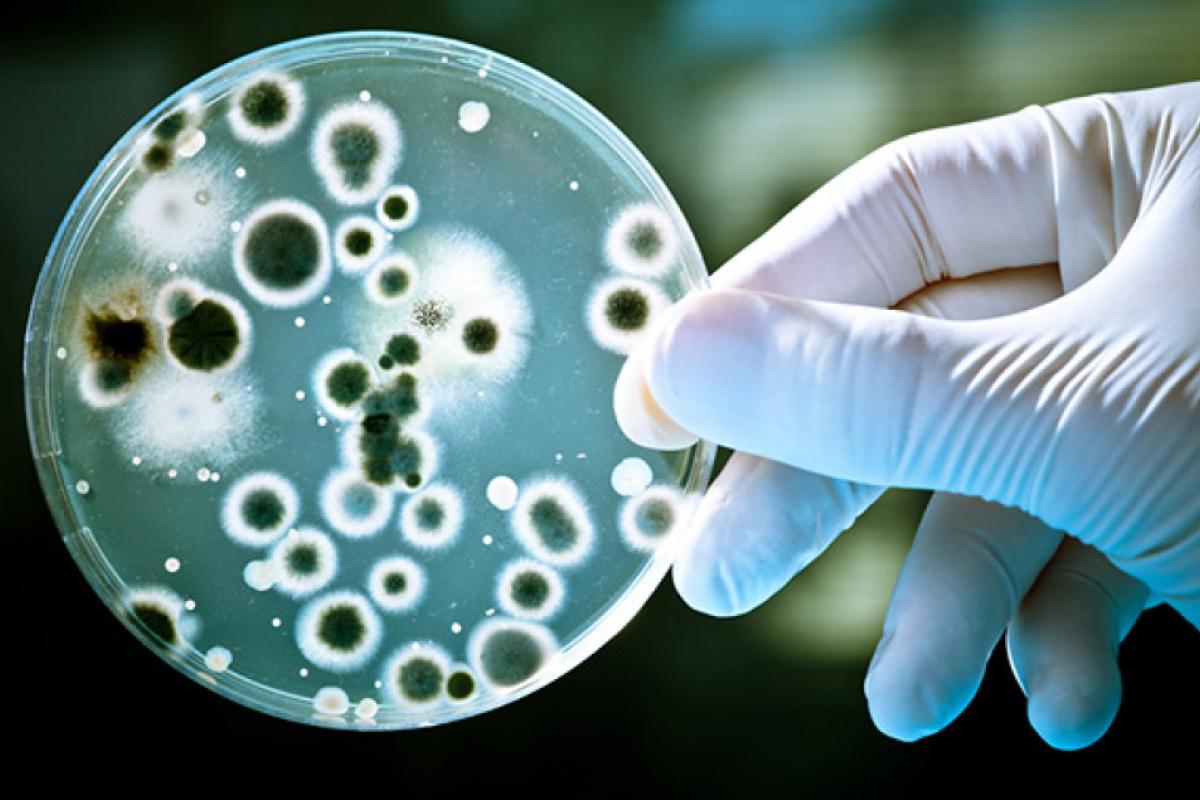
Биолог открыла новый вид грибов по фото в Twitter Биолог открыла новый вид грибов по фото в Twitter

Ана София Реболейра, биолог из Музея естественной истории Копенгагенского университета в Дании, обнаружила новый вид паразитического гриба необычным способом.
Ученая впервые увидела в Твитетре фотографию многоножки, опубликованную американским биологом Дереком Хенненом. На голове существа зоркий глаз Реболейры заметил несколько подозрительных точек.
Биолог заподозрила, что это может быть ранее неизвестный вид грибов. Вместе с коллегой Хенриком Енгоффом она продолжила исследования и обнаружила несколько образцов такого же гриба на нескольких образцах американской многоножки, хранящихся в коллекции Музея естественной истории.
Изыскания привели к к подтверждению существования ранее неизвестного гриба вида Laboulbeniales. К ним относятся более 2000 разновидностей грибов, которые являются эктопаразитами насекомых, клещей и многоножек.
Исследователи назвали вид Troglomyces twitteri в честь социальной сети, где он был обнаружен. Результаты исследования были опубликованы в журнале MycoKeys.
Реболейра надеется, что другие ученые поделятся своими работами и открытиями в социальных сетях. По ее словам, обнаружение нового вида грибов стало первым научным открытием в Твиттере. Она добавляет, что это показывает, насколько важны платформы социальных сетей для обмена исследованиями и достижения новых результатов.
A super cool story came out today! We finally have a species of ectoparasitic fungus known from millipedes in North America, thanks to @SReboleira's keen eyesight. https://t.co/KMaklHpn6t
— Derek Hennen, Ph.D. (@derekhennen) May 14, 2020
















